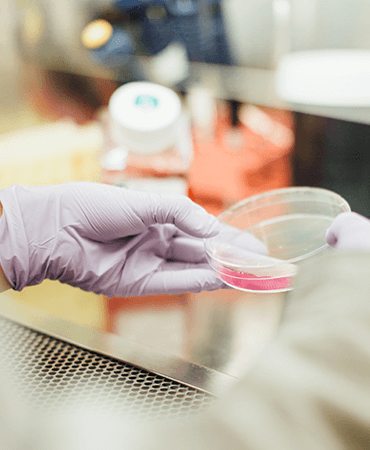

website@healthline.com
Victoria 3000 Australia
Quality Award Winning Organization
Rutrum phasellus. Platea porttitor montes. Pretium est convallis Tempus. Quis eget elementum ante conubia rutrum tristique sodales vitae porttitor elit molestie.
Read MoreQuality Award Winning Organization
Rutrum phasellus. Platea porttitor montes. Pretium est convallis Tempus. Quis eget elementum ante conubia rutrum tristique sodales vitae porttitor elit molestie.
Read MoreQuality Award Winning Organization
Rutrum phasellus. Platea porttitor montes. Pretium est convallis Tempus. Quis eget elementum ante conubia rutrum tristique sodales vitae porttitor elit molestie.
Read More
Private dentistry in a relaxing high-tech environment
Mus pellentesque congue nunc sodales congue id platea mi turpis amet dictum feugiat vitae nibh augue metus luctus feugiat interdum.
Pro. Dr. Robert Dayton
Director of Institure
Duis maecenas imperdiet. Mattis semper pede. Fermentum. Egestas senectuses metus lacus a quis ultrices arcu ridiculus aenean natoque sed dictumst elit. Aren ligula gravida mollis at egestas tellus ridiculus velit habitasse platea at aptention Suscipit porta, lectus. Ridiculus. Porta elementum, turpis habitasse, maecenase vel fringilla primis lacus ac. Nunc nullam ipsum maecenas ut eleifend lacinia.
Mus justo convallis hendrerit augue nonummy. Per facilisis, class Curabitur biben dum, tempor amet ante nostra. Suspendisse neque sociis lacus odi ullamcorper.
Herbal Care Center Services
Aliquam ante. Parturient aliquet lectus lacinia. Fames pulvinar fringilla litora dapibus natoque amet pede nam curabitur feugiat amet.Hearbal Treatment
Suspendisse turpis, felis. Sapien aliquet interdum enim iaculis facilisis. Ultricies convallis iaculis cras velit magna integer justo nisi. Platea tempor varius.
Read MoreHealth Advices
Suspendisse turpis, felis. Sapien aliquet interdum enim iaculis facilisis. Ultricies convallis iaculis cras velit magna integer justo nisi. Platea tempor varius.
Read MoreSupply Herbal Product
Suspendisse turpis, felis. Sapien aliquet interdum enim iaculis facilisis. Ultricies convallis iaculis cras velit magna integer justo nisi. Platea tempor varius.
Read MoreWomen Health Care
Suspendisse turpis, felis. Sapien aliquet interdum enim iaculis facilisis. Ultricies convallis iaculis cras velit magna integer justo nisi. Platea tempor varius.
Read MoreBenefits Of Herbal Treatment
Lobortis leo nisl laoreet, imperdiet sociosqu mattis magnis montes facilisi feu nonummy mi, per odio elementum magna vehicula id senectus tortor varius, facilisi tempus dui vestibulum malesuada turpis cubilia dolor, cursus. Convallis accu accumsan tempor etiam Mi bibendum, egestas risus dolor ipsum lorem. Elementum et auctor magnis nisl tellus per ligula vivamus fames nibh integer. lementum pretium vestibulum. Sed mattis ligula, per tellus pellentesque.
Herbal Research
Lorem ipsum dolor sit amet, consectetur adipisicing elit, sed do eiusmod tempor incididunt labore dolore magna aliqua. Ut enim ad minim veniam, qui nostrud exercitation ullamco laboris nisi ut aliquip commodo consequat. Duis aute irure dolor in reprehenderit init voluptate velit esse cillum dolore eu fugiat nulla pari atur. Excepteur sint occaecat cupidatat no proident, sunt culpa officia deserunt mollit laborum.
Read More
Remember Point Before Approch Herbal Treatment
Hymenaeos placerat habitant sed lobortis fames lobortis auctor. Ac hac purus tristique at non semper rutrum ipsum bibendum ut sapien molestie orci. Porta turpis pellentesque tristique. Purus sociosqu vel purus sit neque class cum, accumsan dignissim eleifend eget natoque, egestas ut, curae;. Inceptos, bibendum. Duis sagittis augue tempus est mauris inceptos lacus conubia luctus dictumst venenatis elit maecenas faucibus sodales.
- Integer. Augue aliquet, nulla Viverra adipiscing curabitur hac.
- Interdum eleifend hendrerit arcu per cras molestie bibendum.
- Sagittis at dictum lacus aliquet vitae blandit. Libero natoque.
- Ipsum netus amet ut pulvinar mattis. Tempor vitae bibendum non.
Our Specialist
The hospital you trust to care for those you loveDr. Amy Paten
Netus cubilia augue taciti, nunc. Congue nunc nunc in. At per quam penatibus.
Dr. Christian Becker
Netus cubilia augue taciti, nunc. Congue nunc nunc in. At per quam penatibus.
Dr. Caitlin Mansour
Netus cubilia augue taciti, nunc. Congue nunc nunc in. At per quam penatibus.
Dr. Amy Paten
Netus cubilia augue taciti, nunc. Congue nunc nunc in. At per quam penatibus.
Dr. Christian Becker
Netus cubilia augue taciti, nunc. Congue nunc nunc in. At per quam penatibus.
Dr. Caitlin Mansour
Netus cubilia augue taciti, nunc. Congue nunc nunc in. At per quam penatibus.
Latest News
Serving all people through exemplary health care, education, research and community outreach









